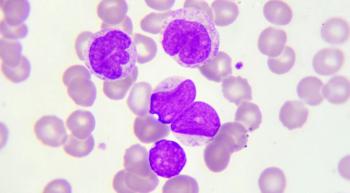

CLL
Latest News









The combination use of Imbruvica (ibrutinib) with Rituxan (rituximab) significantly improved survival outcomes compared with standard of care in younger patients with chronic lymphocytic leukemia (CLL).

Former NFL coach discusses how cancer motivated him to appreciate life.

Single agent Copiktra (duvelisib) induced robust, durable responses in patients with relapsed/refractory chronic lymphocytic leukemia (CLL)/small lymphocytic lymphoma (SLL) who experienced disease progression after treatment with Arzerra (ofatumumab).

Frontline use of Imbruvica (ibrutinib) in combination with Gazyva (obinutuzumab) significantly reduced the risk for disease progression or death among patients with chronic lymphocytic leukemia (CLL) or small lymphocytic lymphoma (SLL), especially in those with high-risk disease.

This week, we spoke with former NFL coach, motivational speaker and acute promyelocytic leukemia survivor Chuck Pagano about his journey with cancer, and what has inspired him to give back following his diagnosis.

In patients with chronic lymphocytic leukemia (CLL) or small lymphocytic lymphoma (SLL), high doses of curcumin and vitamin D could help stabilize the disease, according to new research presented at the American Society of Hematology’s (ASH) Annual Meeting in San Diego.

Administering Imbruvica with CAR-T cell therapy improved outcomes in patients with chronic lymphocytic leukemia, according to recent research.
Regimens containing Imbruvica bested chemoimmunotherapy treatments in elderly patients with chronic lymphocytic leukemia, but less toxic and long-term treatments are still needed.

An oncologist and three advocates were honored for their work on behalf of people with chronic lymphocytic leukemia.

Take a look at the FDA’s decisions for the treatment of SLL that happened this year.

While CAR-T cell therapy has potential in treating CLL, T-cell fatigue and toxicity still raise many concerns.

CLL is the most common type of leukemia in adults across the United State. Here's what you need to know about the disease.

What’s the best plan for lowering cancer drug prices? A panel of experts debated the possibilities.

Imbruvica (ibrutinib) is a safe treatment for patients with chronic lymphocytic leukemia/small lymphocytic lymphoma (CLL/SLL) and mantle cell lymphoma (MCL), according to a pooled analysis of four clinical trials.

Chronic lymphocytic leukemia can now be managed as a long-term condition, and there are new ways loved ones can help.

The FDA has granted a priority designation to a supplemental new drug application (sNDA) for Imbruvica (ibrutinib) for use in combination with Gazyva (obinutuzumab) for the frontline treatment of adult patients with chronic lymphocytic leukemia (CLL) or small lymphocytic lymphoma (SLL).

The drug was approved for adults with chronic lymphocytic leukemia and small lymphocytic lymphoma. And was granted an accelerated approval for follicular lymphoma.




